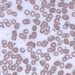
Shorter overall survival among patients with monoclonal gammopathy of undetermined significance

2 Minute Medicine Rewind January 22, 2017
Chagas disease is a major endemic vector-borne disease and global health issue. Currently, there is a paucity of new treatments for Chagas disease, as benznidazole and nifurtimox continue to be the only two pharmacologics used for treatment. The ergosterol biosynthesis inhibitor ravuconazole has been proposed as a new drug for Chagas disease in animal models. In this randomized controlled trial, 231 patients with Chagas disease were randomized to receive placebo (n=47), benznidazole (n=45), high-dose (n=45), low-dose (n=48) or short-dose (n=46) ravuconazole prodrug E1224 to investigate the safety and efficacy of these treatment regiments in patients with chronic indeterminate Chagas disease. The primary outcome evaluated was parasite clearance, as measured using qPCR for parasite DNA. Researchers found that all treatment groups achieved a significant reduction in parasite load when compared to placebo (p<0.0001 for all). Twelve months after treatment, however, qPCR measurements for parasite concentrations in low-dose and short-dose E1224 groups gradually returned to placebo levels (p=0.499 and 0.744, respectively). In contrast, patients in the high-dose E1224 group and benznidazole group demonstrated significantly lower loads than the placebo group (p=0.0015 and p<0.0001, respectively). At 12 months of follow up, 29% of patients in the high-dose E1224 group showed sustained response for parasite clearance (95% CI 16.4% to 44.3%), while 82% of patients on benznidazole had a sustained effect on parasite clearance (95% CI 67.9% to 92.0%). In terms of adverse effects, no deaths occurred, although the benznidazole treatment group had the highest proportion of treatment-emergent adverse events. Overall, as the results show that E1224 elicits only a transiently suppressive response against parasite load, investigators suggested that E1224 would likely be more effective when used in combination with benznidazole as opposed to monotherapy. More studies, however, are needed to determine the safety profile of E1224 in combination with existing drugs.
Hyperthermic Intraperitoneal Chemotherapy in Ovarian Cancer
The current standard of care for ovarian cancer involves surgery to reduce tumor burden followed by cycles of intravenous chemotherapy. Hyperthermic intraperitoneal chemotherapy (HIPEC) introduced during surgery has been proposed as a means of enhancing treatment of ovarian cancer by increasing the sensitivity of cancer to chemotherapy. In this randomized controlled trial, 245 patients with stage III epithelial ovarian, fallopian tube, or peritoneal cancer were randomized to receive interval cytoreductive surgery with or without HIPEC in order to study the effect on recurrence-free survival. Researchers found that after a median follow-up of 4.7 years, 89% of patients in the surgery group and 81% of patients in the surgery-plus-HIPEC group experienced disease recurrence or death (HR 0.66, 95% CI 0.50 to 0.87, p=0.003). Patients in the surgery-plus-HIPEC group had a median recurrence-free survival that was 3.5 months longer, and the probability of recurrence-free survival at 3 years was 17% for this group (95% CI 11% to 26%) compared to 8% for the surgery-only group (95% CI 4% to 16%). In terms of secondary outcomes, survival was significantly greater in the surgery-plus-HIPEC group compared to the surgery-only group (HR 0.67, 95% CI 0.48 to 0.94, p=0.02). The median overall survival was 33.9 months in the surgery group and 45.7 months in the surgery-plus-HIPEC group. In terms of adverse events, no significant differences between the two groups were observed, although both groups had events of abdominal pain, infection, and ileus. In general, the results from this study support the use of HIPEC as a way to improve recurrence-free survival and overall survival for patients with stage III ovarian, fallopian tube, or peritoneal cancer. Further studies are required to determine whether HIPEC can be used in other contexts, such as after primary cytoreductive surgery.
The long-term effects of bariatric surgery, including mortality, have not been well studied. In this retrospective cohort study, investigators compared 8,385 obese patients who received bariatric surgery to 25,155 matched patients who received nonsurgical care for obesity in order to study the effect on all-cause mortality. Of the 8,385 patients who received bariatric surgery, 3,635 underwent laparoscopic banding, 1,388 underwent Roux-en-Y gastric bypass, and 3,362 underwent laparoscopic sleeve gastrectomy. Researchers found that the absolute difference between surgical and nonsurgical groups was 2.51 fewer deaths per 1000 person-years (95% CI 1.86 to 3.15), with an adjusted hazard ratio for mortality of 2.02 (95% CI 1.63 to 2.52) for nonsurgical versus surgical patients. Taken together, results from this cohort study indicate that bariatric surgery is associated with a lower rate of all-cause mortality. It is important to note, however, that matching was performed for age, sex, BMI, and diagnosis of diabetes, but that there were a higher proportion of low socioeconomic status patients in the nonsurgical group, which could be a confounder. Further studies are needed in comparing differences in long-term outcomes for various types of bariatric surgery.
New therapeutic strategies are needed in the treatment of high-grade serous ovarian carcinoma, as most patients relapse after initial cytoreductive surgery and platinum-based chemotherapy due to platinum resistance. The selective ATP-competitive prexasertib (LY2606368) inhibitor of cell cycle kinase 1 and 2 has been proposed as a new therapy for high-grade serous ovarian carcinoma. In this case series study, 28 women with BRCA wild-type high-grade serous ovarian carcinoma were treated with intravenous prexasertib once every 14 days until disease progression, unacceptable toxicity, or withdrawal of consent. The primary outcome studied was an investigator-assessed objective response according to the Response Evaluation Criteria In Solid Tumors (RECIST). Researchers found that the median duration of treatment in these patients was 11.3 months. Based on an intention-to-treat analysis, 33% of participants (95% CI 16% to 55%) had partial tumor responses identified during the first tumor reassessment at 2 months. In terms of platinum resistance, 58% of the 19 patients with platinum-resistant disease had an observed clinical benefit; 32% of the 19 patients (95% CI 13% to 57%) showed partial tumor responses to treatment, while another 26% (95% CI 9% to 51%) had stable disease for at least 6 months. In terms of adverse effects, 79% of patients had transient grade 4 neutropenia after the first dose of prexasertib, while 7% of patients had treatment-related serious adverse events of grade 3 febrile neutropenia. Overall, the results of this study indicate that prexasertib may have some clinical efficacy in patients with BRCA wild-type high-grade serous ovarian carcinoma.
Sleeve gastrectomy is a simpler bariatric surgery than laparoscopic Roux-en-Y gastric bypass. However, the long-term outcomes of sleeve gastrectomy compared to gastric bypass have not been well studied. In this randomized controlled trial, 240 adults with morbid obesity were randomized to undergo laparoscopic sleeve gastrectomy or laparoscopic Roux-en-Y gastric bypass in order to compare effects on percentage excess weight loss at 5 years. Researchers found that the percentage excess weight loss at 5 years was 49% (95% CI 45% to 52%) after sleeve gastrectomy, and 57% (95% CI 53% to 61%) after gastric bypass, corresponding to a difference of 8.2 percentage units (95% CI 3.2% to 13.2%) greater for the patients who received gastric bypass compared to those who received sleeve gastrectomy. However, given the pre-specified equivalence margins of -9 to 9 percentage units, the difference in mean percentage excess weight loss did not meet the study’s criteria for equivalence. The greater weight loss associated with gastric bypass was also not found to be not statistically significant on the basis of the prespecified equivalence margins. In terms of secondary outcomes at 5 years, discontinuation of hypertension medications occurred for a higher percentage of patients in the gastric bypass group (51% versus 29%, p=0.02). Patients from both groups achieved type 2 diabetes remission and showed improvements in quality of life scores, and there was no statistically significant difference between the two groups for these secondary outcomes. Overall, the results of this study indicate that these two bariatric surgeries may have different long-term effects in terms of weight loss and hypertension control, but may also yield similar outcomes in other parameters. More studies are needed to determine what other factors should be weighed when choosing a procedure for a particular patient.
Image: PD
©2018 2 Minute Medicine, Inc. All rights reserved. No works may be reproduced without expressed written consent from 2 Minute Medicine, Inc. Inquire about licensing here. No article should be construed as medical advice and is not intended as such by the authors or by 2 Minute Medicine, Inc.